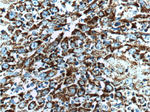
HSP60 Antibody in Immunohistochemistry (Paraffin) (IHC (P))
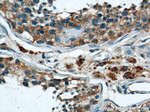
HSP60 Antibody in Immunohistochemistry (Paraffin) (IHC (P))
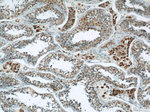
HSP60 Antibody in Immunohistochemistry (Paraffin) (IHC (P))

Search
Proteintech
HSP60 Monoclonal Antibody (2F10E7)
{{$productOrderCtrl.translations['antibody.pdp.commerceCard.promotion.promotions']}}
{{$productOrderCtrl.translations['antibody.pdp.commerceCard.promotion.viewpromo']}}
{{$productOrderCtrl.translations['antibody.pdp.commerceCard.promotion.promocode']}}: {{promo.promoCode}} {{promo.promoTitle}} {{promo.promoDescription}}. {{$productOrderCtrl.translations['antibody.pdp.commerceCard.promotion.learnmore']}}
产品信息
66041-1-IG
种属反应
已发表种属
宿主/亚型
分类
类型
克隆号
抗原
偶联物
形式
浓度
规格
纯化类型
保存液
内含物
保存条件
运输条件
产品详细信息
Immunogen sequence: SPYFINTSK GQKCEFQDAY VLLSEKKISS IQSIVPALEI ANAHRKPLVI IAEDVDGEAL STLVLNRLKV GLQVVAVKAP GFGDNRKNQL KDMAIATGGA VFGEEGLTLN LEDVQPHDLG KVGEVIVTKD DAMLLKGKGD KAQIEKRIQE IIEQLDVTTS EYEKEKLNER LAKLSDGVAV LKVGGTSDVE VNEKKDRVTD ALNATRAAVE EGIVLGGGCA LLRCIPALDS LTPANEDQKI GIEIIKRTLK IPAMTIAKNA GVEGSLIVEK IMQSSSEVGY DAMAGDFVNM VEKGIIDPTK VVRTALLDAA GVASLLTTAE VVVTEIPKEE KDPGMGAMGG MGGGMGGGMF (225-573 aa encoded by BC003030)
靶标信息
This gene encodes a member of the chaperonin family. The encoded mitochondrial protein may function as a signaling molecule in the innate immune system. This protein is essential for the folding and assembly of newly imported proteins in the mitochondria. This gene is adjacent to a related family member and the region between the 2 genes functions as a bidirectional promoter. Several pseudogenes have been associated with this gene. Two transcript variants encoding the same protein have been identified for this gene. Mutations associated with this gene cause autosomal recessive spastic paraplegia 13.
仅用于科研。不用于诊断过程。未经明确授权不得转售。
生物信息学
蛋白别名: 60 kDa chaperonin; 60 kDa heat shock protein; 60 kDa heat shock protein, mitochondrial; chaperonin; chaperonin (HSP60); Chaperonin 60; CPN60; epididymis secretory sperm binding protein; heat shock 60kD protein 1 (chaperonin); heat shock 60kDa protein 1; heat shock 60kDa protein 1 (chaperonin); heat shock 60kDa protein 1 (chaperonin) isoform HSPD1_1; heat shock 60kDa protein 1 (chaperonin) isoform HSPD1_2; heat shock 60kDa protein 1 (chaperonin) isoform HSPD1_4; Heat shock protein; Heat shock protein 60; heat shock protein 60 (liver); heat shock protein 65; Heat shock protein family D member 1; heat shock protein, 60 kDa; HSP; HSP-60; HSP-65; Hsp60s1; HuCHA60; Mitochondrial matrix protein P1; P60 lymphocyte protein; short heat shock protein 60 Hsp60s1; unnamed protein product
基因别名: 60kDa; CPN60; GROEL; HLD4; HSP-60; HSP60; HSP65; HSPD1; Hspd1-30p; HuCHA60; SPG13
UniProt ID: (Human) P10809, (Mouse) P63038, (Rat) P63039
Entrez Gene ID: (Human) 3329, (Mouse) 15510, (Rat) 63868